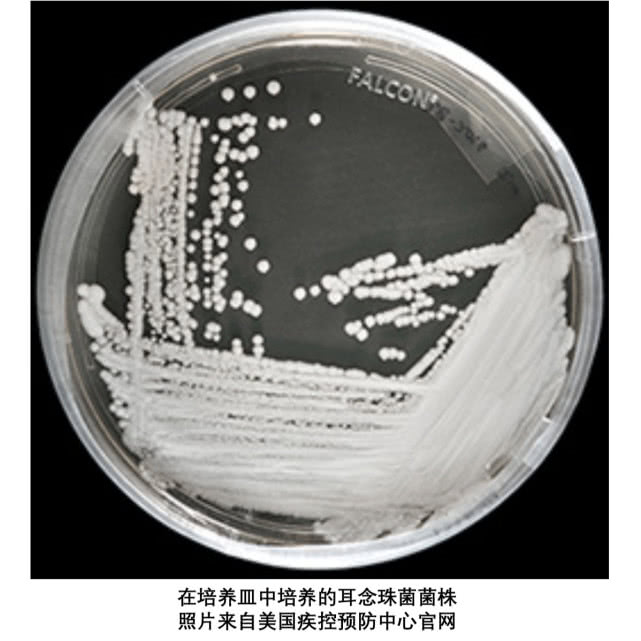
闻臭袜子会感染病毒吗,经常闻臭袜子会引起真菌感染吗

“近日,美国疾控预防中心(CDC)指出,超级真菌-耳念珠菌(Candida auris)目前在全球多处出现,其可能会通过血液传播。美国近期已经发现超过500名患者,近50%的感染者在90天内身亡。”
“各种抗真菌药物治疗无效”“60%致死率”“公共卫生的新威胁”……一种被称为“超级真菌”的耳念珠菌日前刷屏朋友圈,引起一些网友恐慌。闻臭袜子会感染超级真菌吗?“超级真菌”究竟是什么?我们有必要为此恐慌吗?这篇文章就和大家来聊聊关于超级真菌的种种真相。
超级真菌的前世今生
4月9日,科技日报援引美媒报道称,美国疾控预防中心(CDC)指出,超级真菌-耳念珠菌(Candida auris)目前在全球多处出现,其可能会通过血液传播。其中,美国近期已经发现超过500名患者,近50%的感染者在90天内身亡。因为部分耳念珠菌具有多重耐药,血液感染后致死率高的特征,并且在42°C时仍然可以看到良好的生长,所以被称为“超级真菌”。
最早报告这种真菌的是日本帝京大学真菌研究中心科学家们。2005年,他们从一位70岁女性病人的外耳道分泌物里分离出了一种新病原真菌物种,并且在2009年报告了这种真菌。该真菌属于念珠菌的一种,由于在耳道发现,所以学科名称被命名为Candida auris(中文耳念珠,Candida是念珠菌,auris则是拉丁语里耳朵的意思)。此后,该菌株作为耳念珠菌的标准菌株,在世界主要菌株保存组织里保存。

念珠菌是正常的皮肤菌群,在一定条件下(如过度潮湿,正常菌群失调,宿主免疫抑制)可致病。念珠菌病可表现为皮肤皱襞处,如腹股沟、腋下的红斑、脱屑、瘙痒性斑片,以及黏膜、甲周或口角部位的皮损。
从2009年报告第一例病例开始,耳念珠菌已经出现在了世界很多地方,根据分子系统发育分析数据,迄今为止在世界不同地区分离的耳念珠菌菌株按区域分为四个主要分支:1南亚(印度/巴基斯坦/马来西亚),2南非,3南美,4东亚(日本/韩国)。

由于不同进化枝间基因的结构多样性大于其他念珠菌属的结构多样性,理论上最近全球扩散的耳念珠菌菌株属于独立的扩散。简单来说,美国的超级真菌跟我国的超级真菌在基因序列上有所不同,国内目前出现的超级真菌对于抗真菌药物敏感性较强,临床常见的抗真菌药可以控制病情。
病毒、细菌、真菌?傻傻分不清楚?
我们的生活里常常听说细菌感冒和病毒感冒,又时常看到“超级细菌”这个词,这次又来一个“超级真菌”,是不是有一点混乱?
在这里“超级”两个字可以简单理解为:微生物(如细菌、病毒和某些寄生虫)产生能够阻止抗微生物药物(如抗生素、抗病毒药物和抗疟药物)对其产生作用的能力,致使标准治疗方法失去效力。“超级细菌”,也并不是特指某一种细菌,而是泛指那些对多种抗生素具有耐药性的细菌,在医学上又称为“多重耐药性细菌”。
现在,我们就简单来说一下病毒,细菌,真菌的不同:
病毒是一类非细胞型微生物,形体微小,结构简单,无成形细胞核、也无核仁和核膜,除核蛋白体外无其他细胞器;
细菌没有核膜包围形成的细胞核,属于原核细胞型微生物,细菌广泛分布于土壤和水中,或者与其他生物共生;
真菌是一种真核生物,既非植物也非动物。虽然一度将其归入植物但现在将其归入独立的一类生物。

有些真菌只能在显微镜下观察到,如念珠菌等酵母菌以及曲霉菌等霉菌。有些则肉眼可见,如面包霉和蘑菇。真菌可呈圆形(如酵母菌)或长梭型(菌丝)。病毒感染人体后,需要进入宿主细胞才能增殖,细菌则是进入宿主体内后,利用宿主细胞的成分完成自身增殖。真菌则是在人的细胞里,黏膜或者皮肤褶皱处固定下来,菌丝成长,分枝发育。
普通真菌感染,日常生活其实很常见
真菌感染通常分为机会性感染或原发性感染。真菌多为机会致病菌,也就是说致病性弱,宿主免疫能力健康时通常不致病,只在宿主免疫力低下时才致病。引起宿主免疫力低下的原因包括艾滋病、糖尿病、淋巴瘤、白血病、血液系统其他恶性肿瘤、烧伤以及接受皮质激素、免疫*制剂抑**与抗代谢药物治疗。在ICU病房长期住院的患者因为接受医疗操作、自身潜在疾病以及营养不良等原因,出现免疫功能降低,也属于容易被感染人群。
原发性真菌感染主要发生于免疫功能正常的宿主中,这些感染常起因于真菌孢子的吸入,引起局灶性肺炎而成为原发性真菌感染的表现。真菌感染可表现为局灶性或系统性感染。
局灶性感染主要见于皮肤(皮肤真菌感染)、口腔(口炎)和阴道(念珠菌性阴道炎)。系统性感染则会危及内脏,尤其是肺部。此次爆发的耳念珠菌,就是属于系统性感染,其表现为皮肤黏膜病变、真菌血症以及多个部位的局灶性感染。
随着气温的逐渐升高,一种常见的真菌感染--足癣又回到了我们的视野。足癣俗名“脚气”,是一种真菌感染。因为人的足底和趾间没有皮脂腺,从而缺乏抑制真菌的脂肪酸,生理防御机能较差,而皮肤汗腺却很丰富,夏天出汗比较多,加之空气流通性差、局部潮湿温暖,有利于丝状真菌的生长。此外,足底部位皮肤角质层较厚,角质层中的角蛋白是真菌的丰富营养物质,也为真菌的生长提供了合适的条件。所以在夏天,要尽量选择透气的鞋子,注意清洁,保持皮肤干燥,保持足部清洁,来预防脚气发生。
“超级真菌”来袭?我们需要注意什么?
耳念珠菌属于侵袭性的真菌,因其可以侵入血液,心脏,脑等人体重要器官最后危及人体健康。但耳念珠菌属于典型的医院感染细菌,多出现在医院设施里,健康的普通大众并非易感人群。被感染患者多出现在ICU,属于自体免疫极度低下的人群,并且国内目前发现的超级真菌其实对于临床使用的抗真菌药物感受性良好,大家不必过分担心。
比起这个,去年一则新闻不知道大家是否记得?据新闻报道:福建漳州市第909医院接受了这么一位病人,刚开始这名病人说自己经常咳嗽,呼吸有点困难,于是医院给拍了片子后按照普通的肺炎来治疗的。治了一周以后病情反而加重,做了肺部穿刺才发现这名男子是肺部真菌感染,最终确定感染的真菌类型后对症下药,男子的病情逐渐开始好转。
在问及真菌感染的原因时,病人的主治医生解释到,这位病人平常熬夜照看婴儿,虽然家里的环境都很卫生,就是有一个小毛病,脱袜子的时候习惯性闻一下。主要由于这个病人患有脚癣,加上经常熬夜伴随饮食不规律,抵抗力变弱,这样就导致了肺部真菌感染,真菌肺炎可就不是脚气痒那么简单的事情了。所以,注意卫生,勤洗手,袜子最好和衣服分开清洗。
此外,糖尿病患者一定不要忽视脚气问题。糖尿病如果血糖控制不良,容易因为血糖水平高感染足癣,较难治愈。并且糖尿病会导致微血管病变与神经病变,而足部皮肤的小破损或癣病,都可能发展成持久不愈的慢性溃疡。脚气虽然跟糖尿病足没有必然的联系,却是糖尿病足的诱发因素。
注意卫生增强身体免疫力,疾病远离你
“超级真菌能致命”虽然听起来很恐怖,但其实离我们一般健康人群很远,无需要过分担心。超级真菌的易感染人群都是免疫力严重受损的人,如肿瘤放化疗、长期滞留导管的患者等,普通人无需对其过分担心。面对“超级真菌”来袭,我们生活中也要注意自身与环境的卫生状况,改正不良的生活习惯,提高身体免疫力,让疾病离健康远远的。
日常生活中除了闻臭袜子,还有哪些不良习惯和因素容易引起真菌感染呢?欢迎大家留言。
参考文献:
1. PLoS Pathog. 2017 May; 13(5): e1006290. Candida auris: A rapidly emerging cause of hospital-acquired multidrug-resistant fungal infections globally. Anuradha Chowdhary et al
2. Candida auris infection ? the First Fungus-causing Emerging Infectious Diseas— Hideyo YAMAGUCHI 2017【话题:感染症】213
作者:张璞(中) 日本名古屋大学医学院博士
审稿:陆修远(中) 日本大阪大学微生物研究所研究员
编辑:王波
文章由腾讯科普“科普中国头条创作与推送项目”团队推出
转载自科普中国